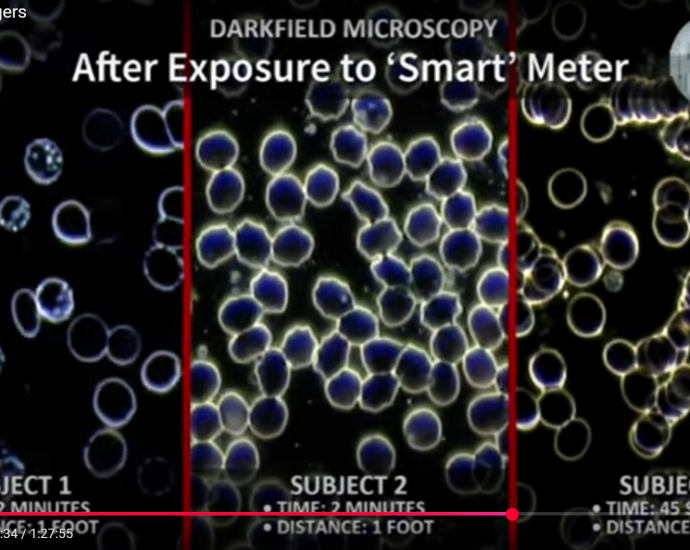

EDF Energy are playing hardball and not accepting our smart meter dangers information. They are so ignorant, even at CEO level. Not only can they not provide any long term safety standards on smart meters, they continue to say that analog meters are no longer produced, all they have is smart meters and our only option is to get it put into dumb mode. However, these machines are smart meters, whether the communication is turned on or off. I do not trust them. MONEY IS THEIR GOD.
Considering the wealth of evidence in this transcribed video, the utilities, Smart Energy GB, worldwide governments, Ofgem and all energy regulators are complicit in harming the health of every single human on this planet, plus all of the animals too.
Bees die, and bees are an important pollinator of food.
Watch Smart Meter Dangers here
Smart Meter Dangers – video transcription
Microwave Power Density Health Effects vs Safety Standards
What are I going to do about it? Well I’m charging EDF £10 per day for their refusal to remove this, and with this level of evidence I have (which covers worldwide as these smart meters are all the same), my family will be getting free gas and electric for as long as I can find a brave gas and electrical engineer to bloody remove them and replace with analog.
Those bastards Ofgem should be hung for lying to consumers and failing to disclose smart meter dangers. This is their page on smart meters. Where the fuck does it mention radiofrequency radiation. It doesn’t.
Same with Smart Energy GB, Energy Saving Trust, Centre for Sustainable Energy, Energy UK, National Energy Action and so many others. Shame on Ross Kemp and Angela Rippon who promote these smart meters. How sad!
There are so many pussy gas and electrical engineers who never even respond to my emails. Where are the real men who actually care about human health, over money and an evil sinister agenda of global surveillance and creating ill and weakened human beings, without people even being given the full facts of the dangers of these smart meters, in order to obtain informed consent?
The Government and these agencies will NEVER tell the truth, just like they had to use the threat of a pandemic to coarse most of the world into taking a ‘vaccine’ that has killed tens of thousands of people worldwide, and damaged millions of people. The level of injustice we humans have had to face is on another level with very little accountability to those committing the evils. I don’t fancy being an agent of the Government and standing before God, because he gave us all a conscience to do right or wrong, and to say ‘I was just doing my job’. Wisdom comes before foolishness and morals before ignorance. Grow some balls, peeps.
According to Crown Energy, it is legal to install your smart meters, as long as it is done by a competent professional.
Can I install my own electricity meter?
You can legally install your own electricity meter, as long as you have the supplier’s permission and the person installing the equipment is qualified to do so. It’s not recommended for anyone not qualified to attempt the installation, as it is a dangerous procedure to undertake.
Source: Crown Energy – FAQ
As far as I can see it, if you have given notice to your energy supplier to remove their meters and instead they tell you not to tamper with them, this is refusal and them being difficult when you have a right. I’m fucking sick of them. Find a competent professional, and get it removed. That’s what I am going to do once I have gotten my first £300 from them through court. There is no way they can rebut any of the evidence found in this video and transcription, and it is my right to protect my family from harm.
These agendas are so sinister. They are all about CONTROL, SURVEILLANCE, because the current god of this world is Satan and he needs to control everyone, and he uses these pussy organisations who accept his money to do it all for them, LYING TO THE PUBLIC, COERCING THE PUBLIC BY MAKING THE PUBLIC FEEL LIKE THEY ARE HELPING TO ‘SAVE THE PLANET’.
These lies have to stop, and if you are working for any of these smart meter praising organisations or websites, wake up. You are being used, and the smart meter you have installed is harming you too.
Check it out.
Dr. De Kun Li, MD, PhD, MPH, Senior Research Epidemiologist, Kaiser Permanente Division of Research]
I’m not aware of any safety studies that have been done to examine the safety of a smart meter. To me, a manufacturer wants to give a product to a consumer, especially in this case to everybody, imposed on everybody. They are the ones who should carry the burden to prove it is safe before they can give it to other people.
It’s not up to the consumer to demonstrate they are unsafe.
[Dietrich Klinghardt, MD, PhD, Founder, Sophia Health Institute, Founder Klinghardt Academy]
It is our experience as physicians that everybody is equally electrosensitive. You install this thing, measurably, certain things in your health go down. We’re tracking now certain sensitive parameters of it. One is an inflammatory marker called TGF-Beta-1. It goes way, way up as soon as the smart meter is installed. The MMP-9, the metalloproteinases, go way, way up. These are inflammatory markers. The copper level in the serum goes up as a sign of chronic inflammation driven by something that’s suddenly there. And the hormones go way up. The neurotransmitters go way up.
So we have lab tests that we can show. Here’s a patient. We monitor him. For 10 years before, he was completely normal. The smart metre was installed. Six months later, the patient looks like a dying patient from the lab work. And we find those changes even in people that say, Well, my wife is sick since the smart meter’s in there, but I’m totally healthy. When we look at the lab work, it looks just as bad.
So some people have an awareness of health and goodness in them, and other people don’t. But from what our experience is that everybody is affected by this, not just a few 3% of electrosensitive people.
[Josh Del Sol, Director]
Did you hear about people coming to you as far as having complaints about illness?
[Dr. Frank H Springob, DC, Chiropractic Physician and Author]
We were made aware of health complaints following installation of smart meters, and we wanted to verify this using our field work. So I measured the field of about 30 different people while they stood one foot in front of the smart meter. And in every single case, the human energy field was obliterated as they stood in front of the smart meter.
We wanted to then verify this at the physical level using dark field microscopy. And then we also did a control group to find out if the old analogue meter had the same effect on the blood as the smart meter. So in our first slides, what we see is normal cells and the structure of the cells is intact and sound. This is what we would expect from a normal sample.
With the subject standing one foot in front of the analogue meter, there were no significant changes to these blood samples in any of the three that we tested.
In our second set of tests, we’re using the smart meter. Before the exposure, we see the same thing as we saw in the first samples. Normal cell walls, fairly separated, and looking healthy. So after two minutes of exposure in front of the smart metre at about one foot away, we see a totally different story.
Sample 1, you can see a lot of degradation in the cells. The cell walls have been broken, and you see changes in the cells, which are called mycoplasma. It shows a mutation to the cell.
In the second sample, we see a different type of degradation to the cell membranes. You can see a corrugation here. This is called bottle cap formation, and it’s known that this occurs due to oxidation or exposure to free radicals.
So this third subject, when we did her sample, she had to be pulled away from the metre after 45 seconds because she complained about an increasingly severe headache. And here you see a phenomenon called Rouleau, where the red blood cells are stacking up, which makes it very difficult for the blood to deliver oxygen to the tissues as they would be their normal function. Every single one of these is a degradation.
Every single one of these shows a trauma to the blood cells that came from something, and the only variable was the smart meter. The good news in all this is the patient and the blood can return to normal once they have been removed from the influences of these stressors.
[Josh Del Sol, Director]
So this thing about electrosensitive, 3% or 5% of people are affected and everyone else is OK, what do you have to say about that?
[Dr. Frank H Springob, DC, Chiropractic Physician and Author]
There are changes whether they feel them or not. Maybe they’re not out there complaining about it or trying to make other people aware of what it’s doing to them, yet they’re still being affected by it.
Please people, if you are concerned about smart meter dangers, raise a complaint with your supplier. They will fob you off, as per usual, but start charging them per day for refusing to remove them and replace with analog. If all they care about is money, over human health, then hit them where it hurts. Ask them to rebut the evidence in the transcribed video. If they can’t – pay up and continue to pay up month after month after month. That’s what I intend to do until I can get these meters out. See my letter template in this post. Of course old electric meters are still being produced. See this website. And gas too. See this website.